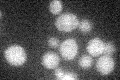
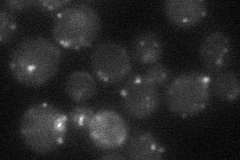
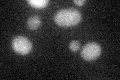

View description
Medium chain fatty acyl-CoA synthetase, activates imported fatty acids; accepts a wide range of fatty acid chain lengths with a preference for medium chains, C9:0-C13:0; localized to the peroxisome
Localization:
Intensity:
Fold change:
Significance:
-
C’ GFP library in SD
below threshold17.52 -
N' NOP1pr-GFP in SD

punctate92.5887 -
N' TEF2pr-mCherry in SD

punctate148.875 -
N' NATIVEpr-GFP in SD
punctate19.6154 -
N' TEF2pr-VC and Cyto-VN in SD

punctate25.1883 -
C’ GFP library in SD+DTT
cytosol14.270.81No -
C’ GFP library in SD+H2O2

cytosol17.541No -
C’ GFP library in Starvation Media

cytosol16.710.95No -
C’ GFP library on the background of Pup2-DaMP

below threshold -
C’ GFP library on the background of CCT mutant

below threshold15.79850.901685No
